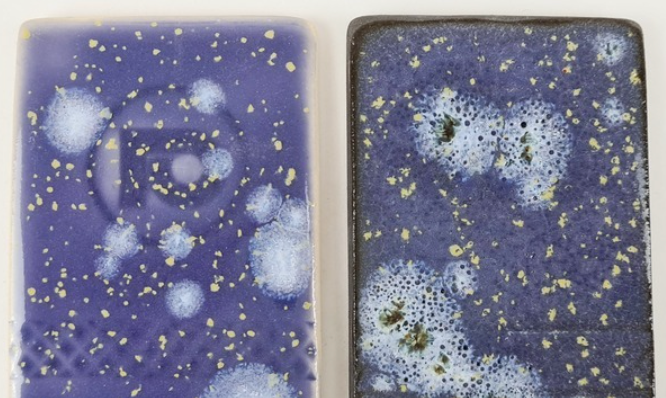

1
/
of
18
Mission Makers Art
PreOrder: Custom Novel-Tea CHOOSE YOUR HOBBY Mug
PreOrder: Custom Novel-Tea CHOOSE YOUR HOBBY Mug
Regular price
$44.00 USD
Regular price
Sale price
$44.00 USD
Unit price
/
per
Couldn't load pickup availability
What do you love? Let's customize a mug around it! Work with Stacy to customize your favorite animals, botanicals, crafts, fruits, games, or hobbies - from yoga and biking to mahjong and reading, and of course dogs, birds, crystals and celestials! Whatever your obsessions and favorite color, we'll work together to make a mug just right for you.
A great gift, too! Turn around time: around 4-6 weeks to delivery. Stacy will e-mail you after purchase to coordinate your options.
Stacy's ceramics are all dishwasher-friendly and microwave safe, though we recommend hand washing to retain the highest quality product over time.
Share